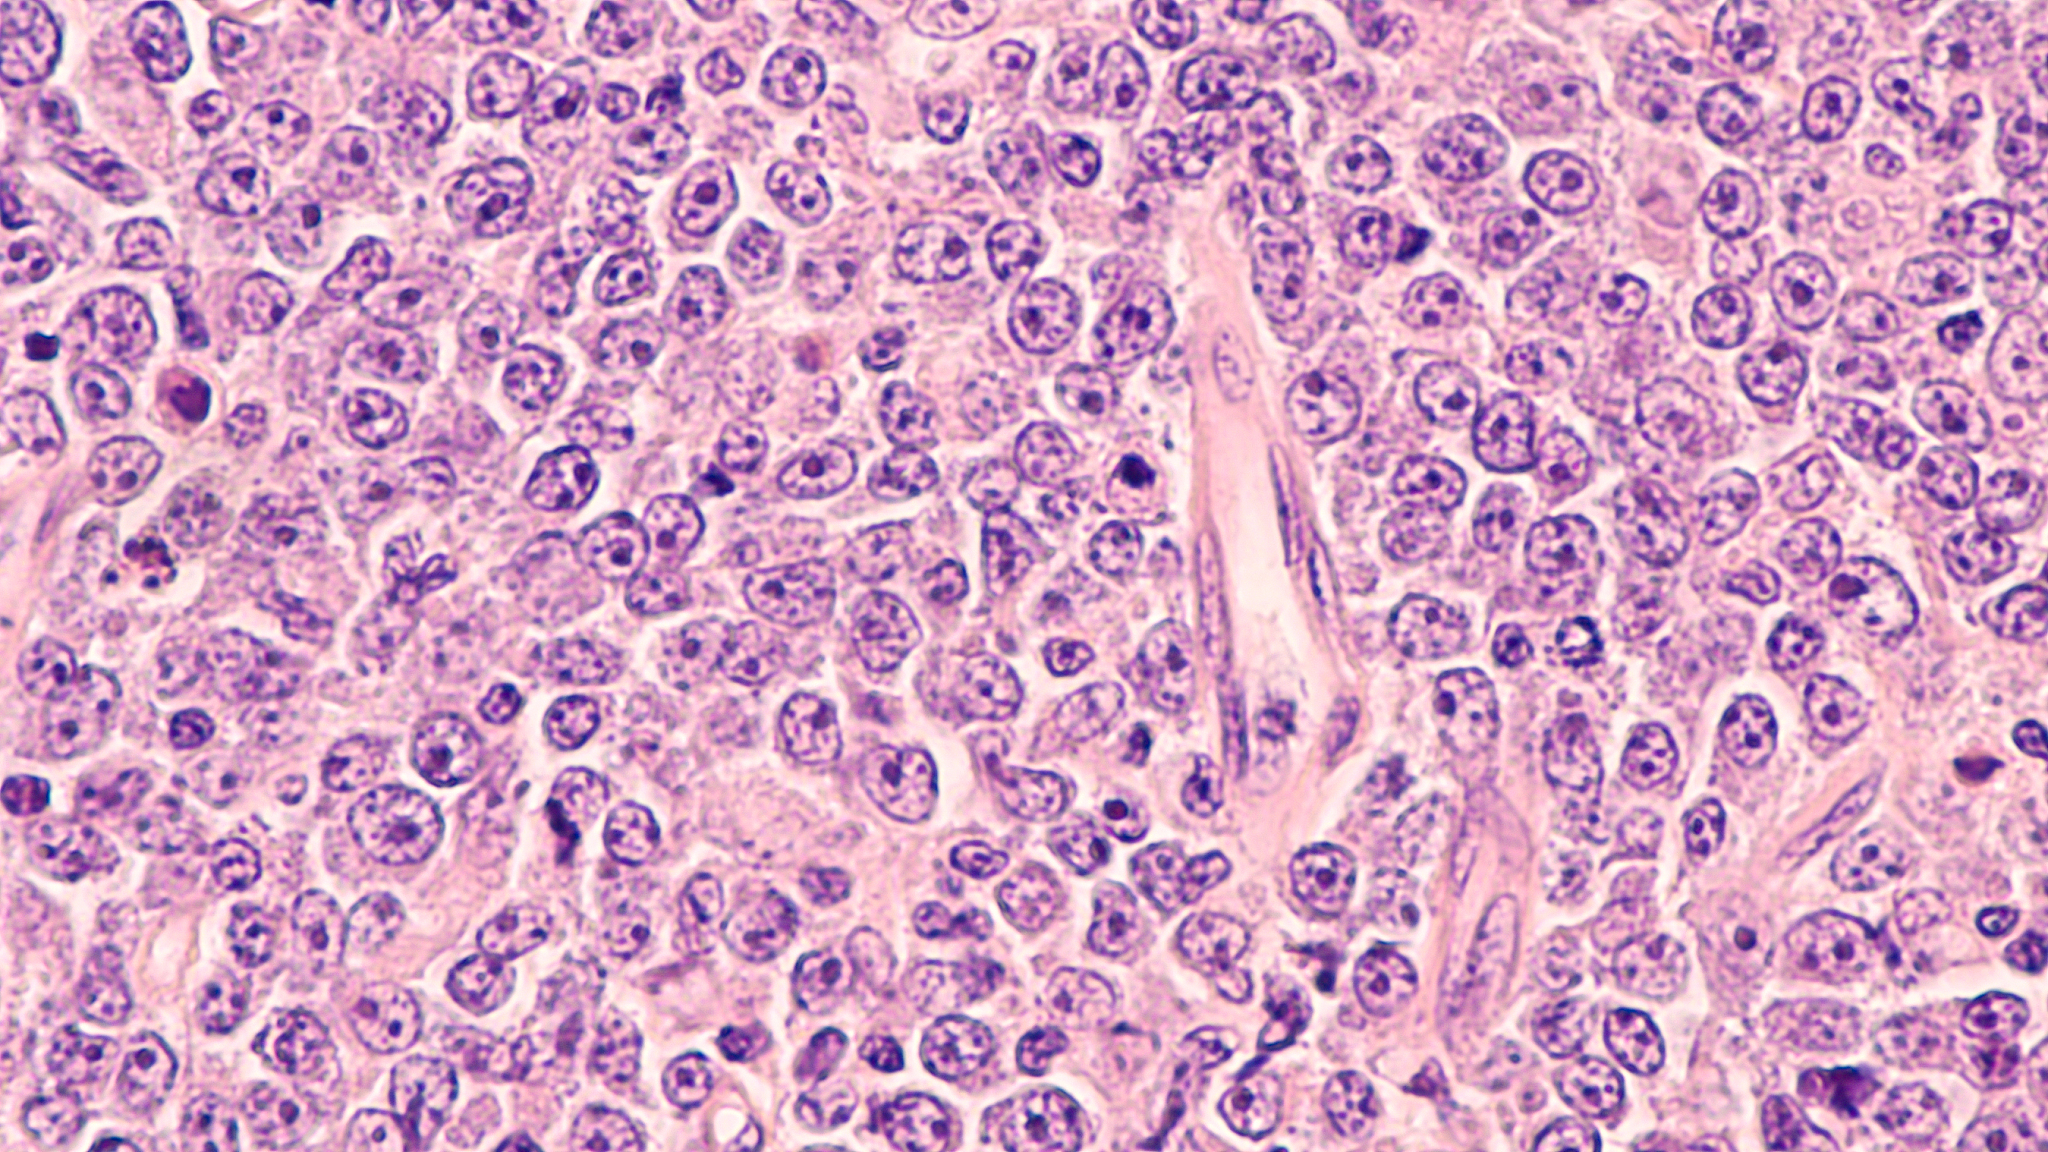
写一段参选文字突出：1各位主任都是临床我希望作为实验室一员给青委会增加一点色彩；2我擅长白血病、淋巴瘤、免疫缺陷病的流式诊断可以帮助大家解决疑难诊断问题；3青委超龄之前奉献余热计划完善全省流式诊断标准化培训提升各家单位血液肿瘤诊断水平策划临床与诊断交流相关的会议请科研高手一起参与

写一段参选文字突出:1各位主任都是临床我希望作为实验室一员给青委会增加一点色彩;2我擅长白血病、淋巴瘤、免疫缺陷病的流式诊断可以帮助大家解决疑难诊断问题;3青委超龄之前奉献余热计划完善全省流式诊断标准化培训提升各家单位血液肿瘤诊断水平策划临床与诊断交流相关的会议请科研高手一起参与
尊敬的各位评委,大家好!
我是一名热衷于临床实验室工作的医生,非常希望能成为青年委员会的一员,为其增添一点色彩。作为实验室的一员,我充满激情和热忱,希望能够与各位主任们共同努力,为血液肿瘤方面的疑难诊断问题提供解决方案。
在我个人的专长方面,我擅长于白血病、淋巴瘤以及免疫缺陷病的流式诊断。经过多年的实践经验和持续学习,我对这些疾病的诊断方法和技术有着深入的理解和熟练的操作能力。我相信,我的专业知识和技能可以为青年委员会带来新的视角和解决问题的能力。
作为一名青年委员,我不仅仅希望在个人的专业领域中有所贡献,更希望能够在超龄之前奉献出自己的余热。我计划通过完善全省流式诊断的标准化培训,提升各家单位的血液肿瘤诊断水平。我还有一个策划,那就是举办临床与诊断交流相关的会议,希望能邀请一些科研高手加入,共同探讨并解决临床实践中的难题。
我相信,我的专业知识、积极性和团队合作精神将会为青年委员会带来新的活力和创造力。我期待与各位主任一起合作,共同推动血液肿瘤领域的发展和进步。
谢谢大家!
原文地址: https://www.cveoy.top/t/topic/ifSj 著作权归作者所有。请勿转载和采集!